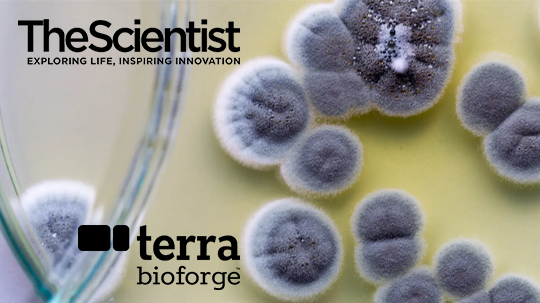

World Class Expertise
Terra Bioforge, formerly Varigen Biosciences, is leveraging a portfolio of breakthrough proprietary tools and
technology assets to scale production of microbial natural products faster and more efficiently.


Accelerating Natural Product Discovery & Production through Metabologenomics, BGC Cloning, & Genome Engineering